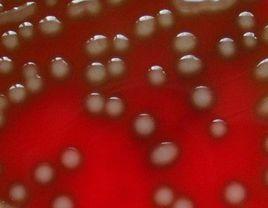
革蘭氏陽性菌 革蘭氏陽性菌

簡介
革蘭氏陽性菌自然界存在多種多樣病菌,如何將這些病菌加以鑑別、分類,並選擇有效藥物進行治療這是很重要的問題。
1884年革蘭氏染色法被發明,用於細菌的形態觀察和分類,根據革蘭氏染色反應的基本特徵,細菌可以主要分為兩大類:G陽性(G)和G陰性(G)。前者經過染色後細菌細胞仍然保留初染結晶紫的藍紫色,後者經過染色後細菌細胞則先脫去了初染結晶紫的顏色,帶上了複雜蕃紅或沙黃的紅色。
細胞形態和結構
細胞的基本結構包括細胞壁和原生質體兩部分。原生質體位於細胞壁內,包括細胞膜(細胞質膜)、細胞質、核質和內含物。另外細胞還含有有些特殊結構,主要有莢膜、芽孢、鞭毛和菌毛等4種。
1.細胞壁
革蘭氏染色的機理主要是抓住了革蘭氏陽性細菌與陰性細菌在細胞壁的結構與組成上的不同,具體比較見下表:
進一步的,革蘭氏陽性細菌的細胞壁主要由肽聚糖和包括磷壁酸的酸性多糖構成,細胞表面整體帶負電的部分原因就是因為磷壁酸帶負電。同時,磷壁酸賦予了革蘭氏陽性細菌以特異的表面抗原。
總的說來,細胞壁結構的差異導致了染料吸收的差異,也導致了很多生理特性的不同。
2.非細胞壁結構
| 性質 | 革蘭氏陽性細菌 | 革蘭氏陰性細菌 | ||
| 內壁層 | 外壁層 | |||
| 結構 | 厚度(nm) | 20~80 | 2~3 | 8 |
| 層次 | 單層 | 多層 | ||
| 肽聚糖關係 | 多層,75%亞單位交聯,網路緊密堅固 | 單層,30%亞單位交聯,網路較疏鬆 | ||
| 與細胞膜關係 | 不緊密 | 緊密 | ||
| 組成 | 肽聚糖 | 占細胞乾重的40%~90% | 5%~10% | 無 |
| 磷聚(酸)酯 | 有或無 | 無 | 無 | |
| 多糖 | 有 | 無 | 無 | |
| 蛋白質 | 有或無 | 無 | 有 | |
| 脂多糖 | 有 | 有或無 | 11%~22% | |
在非細胞壁結構中,革蘭氏陽性細菌和陰性細菌主要的區別在於是否有芽孢和鞭毛與性菌毛的不同上。
芽孢是某些細菌菌體發育過程中的一個階段,在一定的環境條件下由於細胞質和核質的濃縮凝集形成的一種特殊結構。革蘭氏陰性細菌中沒有會形成芽孢的菌種,而部分革蘭氏陽性細菌可以。
另外,在鞭毛和性菌毛方面兩者也有不同。鞭毛和性菌毛都是附屬物。某些細菌表面伸出的細長、波曲的附屬物稱為鞭毛。(顧夏生,胡洪營,文湘華,王慧等.水處理生物學.北京:中國建築工業出版社.2010年.P16)革蘭氏陽性細菌的鞭毛上基本著生兩個環,革蘭氏陰性細菌則基本著生四個環。(趙開弘.環境微生物學.武漢:華中科技大學.2009年.P30)性菌毛只見於革蘭氏陰性菌,參與細胞間稱作接合作用的交配過程。
生理特性
以下是關於革蘭氏陽性細菌和陰性細菌在生理特性方面的比較。兩者的不同從本質上來說,還是主要是由細胞結構的不同所決定的。
| 項目 | 革蘭氏陽性細菌 | 革蘭氏陰性細菌 |
| 對機械力的抗性 | 強 | 弱 |
| 細胞壁抗溶菌酶 | 弱(敏感) | 強(不敏感)* |
| 對青黴素、磺胺 | 敏感 | 不敏感* |
| 對鏈黴素、氯黴素、四環素 | 不敏感 | 敏感 |
| 對鹼性染料的抑菌作用 | 強 | 弱* |
| 對陰離子去污劑 | 敏感 | 不敏感* |
| 對疊氮化鈉 | 敏感 | 不敏感 |
| 對乾燥 | 抗性強 | 抗性弱 |
*細胞壁最外層的脂多糖阻礙溶菌酶、抗生素、染料、去污劑等較大分子進入
常見的革蘭氏陽性菌
革蘭氏陽性菌常見的革蘭氏陽性菌有:葡萄球菌(Staphylococcus)、鏈球菌(Streptococcus)、肺炎雙球菌、炭疽桿菌、白喉桿菌、破傷風桿菌等;常見的革蘭氏陰性菌有痢疾桿菌、傷寒桿菌、變形桿菌、及霍亂弧菌等。
在治療上,大多數革蘭氏陽性菌都對青黴素敏感(結核桿菌對青黴素不敏感);而革蘭氏陰性菌則對青黴素不敏感(但奈瑟氏菌中的流行性腦膜炎雙球菌和淋病雙球菌對青黴素敏感),而對鏈黴素、氯黴素等敏感。所以首先區分病原菌是革蘭氏陽性菌還是陰性菌,在選擇抗生素方面意義重大。
結構特點
革蘭氏陽性菌的細胞壁革蘭氏陽性菌細胞壁較厚,約20~80nm。肽聚糖含量豐富,有15~50層,每層厚度1nm,約占細胞乾重的50~80%。此外,尚有大量特殊組份磷壁酸(teichoic acid)。磷壁酸是由核糖醇(ribitol)或甘油(glycerol)殘基經由磷酸二鍵互相連線而成的多聚物。磷壁酸分壁磷壁酸(wall teichoic acid)和膜磷壁酸(membrane teichoic acid)兩種,前者和細胞壁中肽聚糖的n-乙醯胞壁酸連結,膜磷壁酸又稱脂磷壁酸(lipteichoic acid)和細胞膜連結,另一端均游離於細胞壁外。磷壁酸抗原性很強,是革蘭氏陽性菌的重要表面抗原;在調節離子通過粘肽層中起作用;也可能與某些酶的活性有關;某些細菌的磷壁酸,能粘附在人類細胞表面,其作用類似菌毛,可能與致病性有關。此外,某些革蘭氏陽性菌細胞壁表面還有一些特殊的表面蛋白,如a蛋白等,都與致病有關。
G+菌細胞壁示意圖革蘭氏陽性菌和革蘭氏陰性菌的細胞壁結構顯著不同,導致這兩類細菌在染色性、抗原性、毒性、對某些藥物的敏感性等方面的很大差異。
革蘭氏染色的結果取決於細菌細胞壁的結構即革蘭氏染色原理為:G﹢菌:細胞壁厚,肽聚糖網狀分子形成一種透性障,當乙醇脫色時,肽聚糖脫水而孔障縮小,故保留結晶紫-碘複合物在細胞膜上。呈紫色。
Gˉ菌:肽聚糖層薄,交聯鬆散,乙醇脫色不能使其結構收縮,其脂含量高,乙醇將脂溶解,縫隙加大,結晶紫-碘複合物溶出細胞壁,沙黃復染後呈紅色。革蘭氏陽性菌細胞壁厚約20-80nm,有15-50層肽聚糖片層,含20-40%的磷壁酸。革蘭氏陰性菌細胞壁厚約10nm,僅2-3層肽聚糖,另外還有脂多糖、細菌外膜和脂蛋白。
G-菌細胞壁示意圖放線菌(Actinomycete)是另一大類革蘭氏陽性菌,根據DNA中鳥嘌呤(G)和胞嘧啶(C)的含量,放線菌被稱為高G+C革蘭氏陽性菌,而厚壁菌被稱為低G+C革蘭氏陽性菌。如果細胞的第二層膜是衍生特徵,這兩類革蘭氏陽性菌可能是細菌基部的分支,否則它們可能組成關係相對較近的單系群。它們被認為可能是古細菌和真核生物的祖先,因為它們都缺乏第二層膜,並且具有一些生化上的相似性,比如含有固醇類。此外,儘管恐球菌-棲熱菌(Deinococcus-Thermus)類細菌結構上類似革蘭氏陰性菌,但也可被染成革蘭氏陽性
原理學說
革蘭氏染色原理目前有三種觀點:等電點學說、化學學說和滲透學說。
等電點學說
革蘭氏陽性菌的等電點在pH2-3,比陰性菌(pH4-5)低,加之碘為弱氧化劑,可降低革蘭氏陽性菌的等電點,致使兩類菌的等電點差異擴大,因此陽性菌和鹼性染料的結合力比陰性菌更強。
化學學說
碘液在菌體內與結晶紫結合後又和菌體核心糖核酸鎂鹽-蛋白質複合物結合,此結合物不易被丙酮酒精脫掉,呈革蘭氏染色陽性。因革蘭氏陰性菌缺乏核糖核酸鎂鹽,故對碘與結晶紫結合物攝取少,且不牢固,易被丙酮酒精脫色而呈革蘭氏染色陰性。
滲透學說
乙醇使陽性菌所含粘肽多糖脫水而致細胞壁間隙縮小,通透性降低,在菌體內保留了染料-碘複合物,呈紫色。陰性菌含粘肽少,細胞壁變化不大,通透性不受影響,菌體內的染料-碘複合物較易透出,失去紫色,被復染成為紅色。